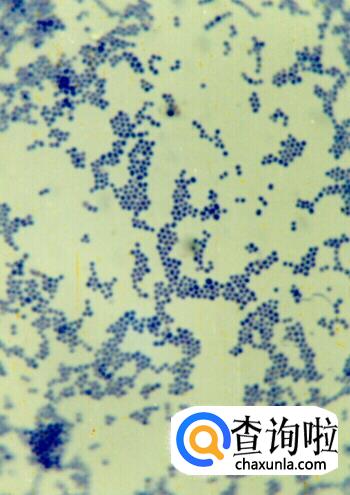
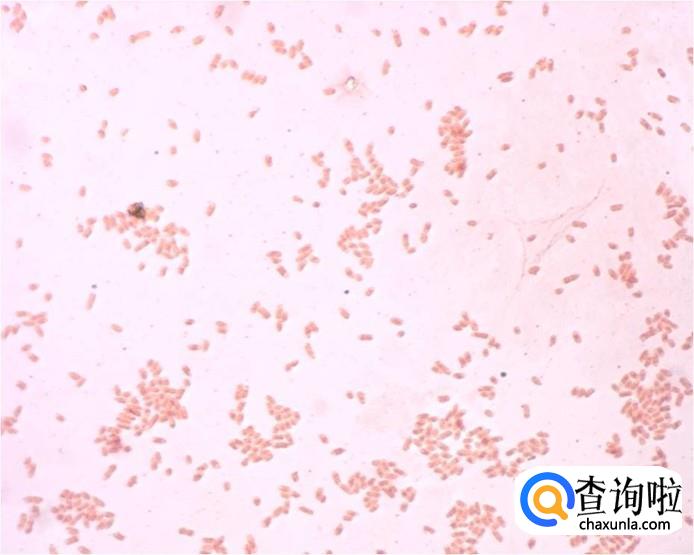

最佳回答
本文由作者推荐
简要回答
详细内容
- 01
载玻片纱布擦干,涂菌部位火焰除油。

- 02
把菌液涂抹在载玻片上,接种环要在火焰中灭菌。

- 03
让涂片自然干燥。

- 04
菌膜朝上,用火焰固定2-3次。

- 05
把固定过的图片放报纸上,加草酸铵结晶液,染色1分钟。
- 06
用水缓慢冲洗载玻片上的染色液,吸水纸吸干。

- 07
加一滴碘液,染色1分钟,水洗。

- 08
吸残留水,加95%乙醇脱色半分钟,流出液体无紫色后,立即水洗。

- 09
加蕃红染色四分钟,水洗。
革兰氏染色完成,观察即可。
- 010
革兰氏阳性菌为蓝紫色,阴性菌为红色。

广告位
点击排行
- 2 排行
- 3 排行
- 4 排行
- 5 排行
- 6 排行
- 7 排行
- 8 排行
- 9 排行
- 10 排行
热点追踪
广告位





















